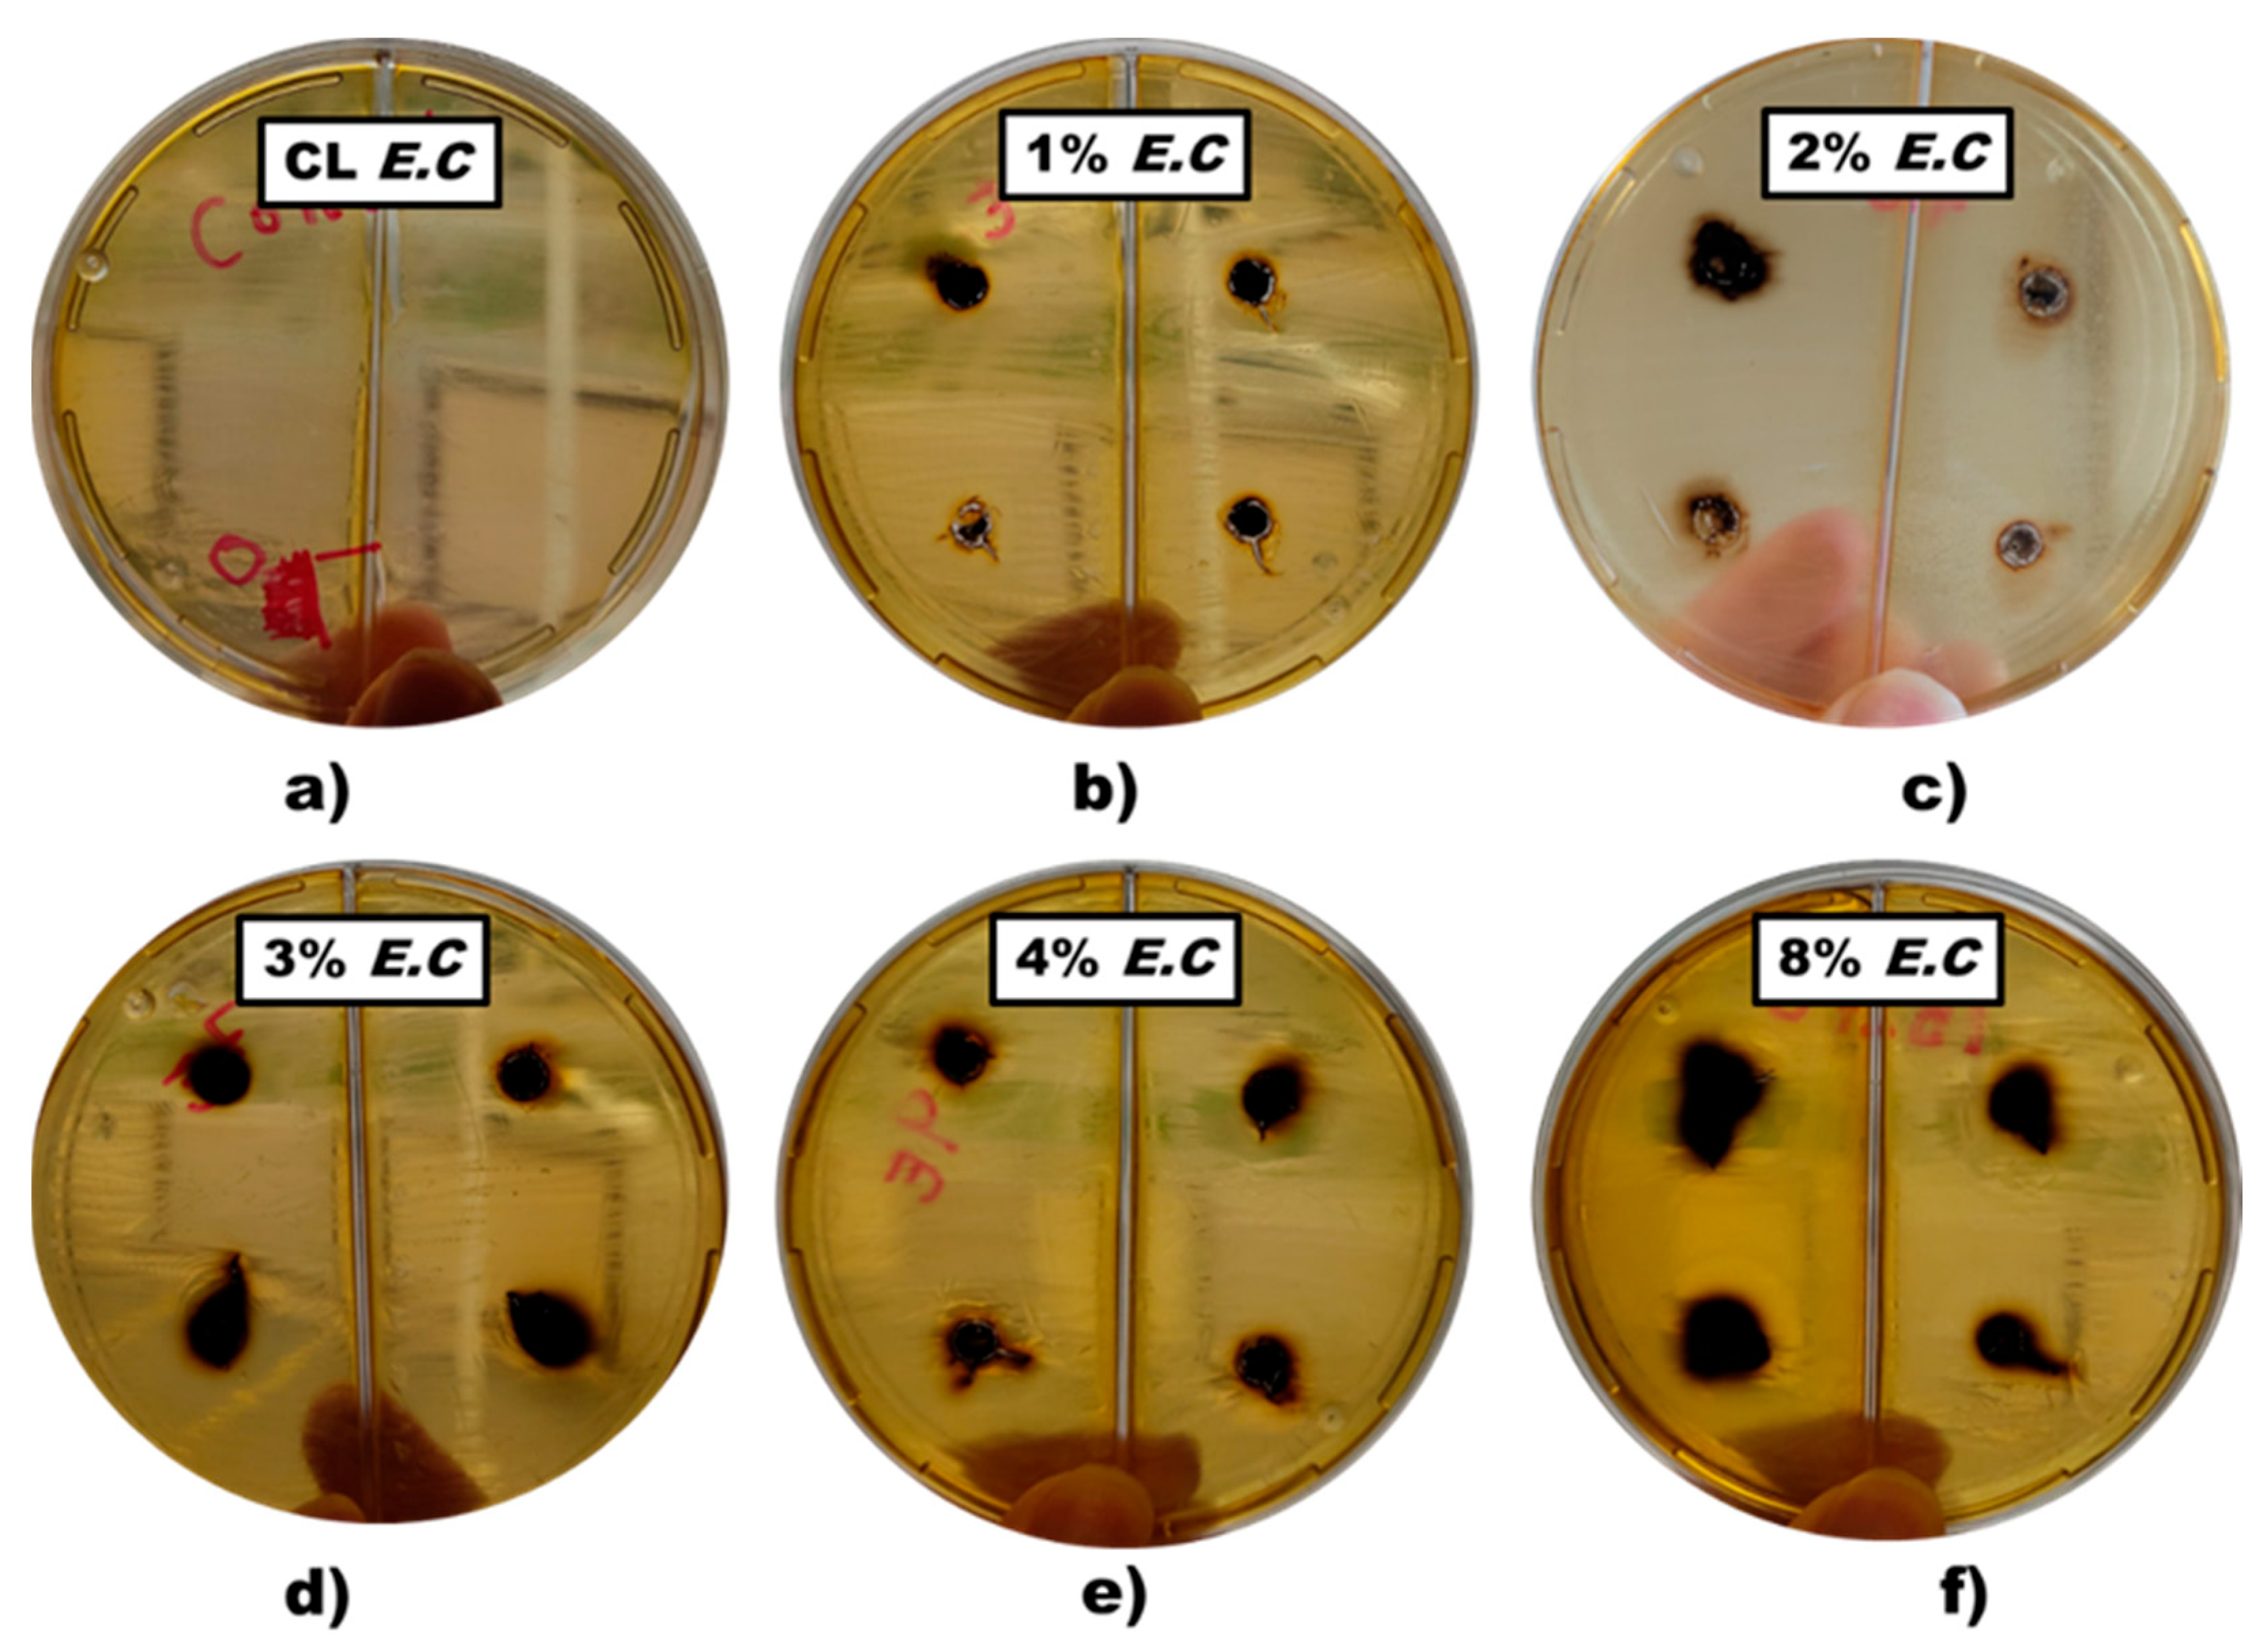
Nanomaterials 14 01151 g009 Nanomaterials 14 01151 g009

Synthesis and Superficial Modification “In Situ” of Copper Selenide (Cu2-x Se) Nanoparticles and Their Antibacterial Activity
Abstract
1. Introduction
2. Materials and Methods
2.1. Materials
2.2. Synthesis of Copper Selenide (Cu2-x Se) Nanoparticles
2.3. Antimicrobial Analysis
2.4. Characterization Techniques
3. Results and Discussion
3.1. X-ray Diffraction Analysis of Copper Selenide (Cu2-x Se) Nanoparticles
3.2. Fourier Transformed Infrared Spectroscopy (FTIR)
3.3. Thermogravimetric Analysis (TGA)
3.4. Differential Scanning Calorimetry (DSC)
3.5. Transmission Electronic Microscopy (TEM)
3.6. Antimicrobial Sensitivity
4. Conclusions
Author Contributions
Funding
Data Availability Statement
Acknowledgments
Conflicts of Interest
References
- Jardón-Maximino, N.; Pérez-Alvarez, M.; Cadenas-Pliego, G.; Lugo-Uribe, L.E.; Cabello-Alvarado, C.; Mata-Padilla, J.M.; Barriga-Castro, E.D. Synthesis of Copper Nanoparticles Stabilized with Organic Ligands and Their Antimicrobial Properties. Polymers 2021, 13, 2846. [Google Scholar] [CrossRef] [PubMed]
- Cota-Ungson, D.; González-García, Y.; Cadenas-Pliego, G.; Alpuche-Solís, Á.G.; Benavides-Mendoza, A.; Juárez-Maldonado, A. Graphene–Cu Nanocomposites Induce Tolerance against Fusarium oxysporum, Increase Antioxidant Activity, and Decrease Stress in Tomato Plants. Plants 2023, 12, 2270. [Google Scholar] [CrossRef] [PubMed]
- Jardón-Maximino, N.; Cadenas-Pliego, G.; Ávila-Orta, C.A.; Comparán-Padilla, V.E.; Lugo-Uribe, L.E.; Pérez-Alvarez, M.; Tavizón, S.F.; Santillán, G.d.J.S. Antimicrobial Property of Polypropylene Composites and Functionalized Copper Nanoparticles. Polymers 2021, 13, 1694. [Google Scholar] [CrossRef] [PubMed]
- Gaetke, L.M.; Chow-Johnson, H.S.; Chow, C.K. Copper: Toxicological relevance and mechanisms. Arch Toxicol. 2014, 88, 1929. [Google Scholar] [CrossRef] [PubMed]
- Harishchandra, B.D.; Pappuswamy, M.; Antony, P.U.; Shama, G.; Pragatheesh, A.; Arumugam, V.A.; Periyaswamy, T.; Sundaram, R. Copper Nanoparticles: A Review on Synthesis, Characterization and Applications. Asian Pac. J. Cancer Biol. 2020, 5, 201–210. [Google Scholar] [CrossRef]
- Pulkkinen, P.; Shan, J.; Leppänen, K.; Känsäkoski, A.; Laiho, A.; Järn, M.; Tenhu, H. Poly (ethylene imine) and Tetraethylenepentamine as Protecting Agents for Metallic Copper Nanoparticles. ACS Appl. Mater. Interfaces 2009, 1, 519–525. [Google Scholar] [CrossRef] [PubMed]
- Bisht, N.; Phalswal, P.; Khanna, P.K. Selenium nanoparticles: A review synthesis and biomedical applications. Mater. Adv. 2022, 3, 1415–1431. [Google Scholar] [CrossRef]
- Zhu, M.; Niu, G.; Tang, J. Elemental Se: Fundamentals and its optoelectronic applications. J. Mater. Chem. C 2019, 7, 2199–2206. [Google Scholar] [CrossRef]
- Mbewana-Ntshanka, N.G.; Moloto, M.J.; Mubiayi, P.K. Antimicrobial activity of the synthesized of copper chalcogenide nanoparticles. J. Nanotechnol. 2021, 2021, 6675145. [Google Scholar] [CrossRef]
- Khan, M.M. Introduction and fundamentals of chalcogenides and chalcogenides-based nanomaterials. In Chalcogenide-Based Nanomaterials as Photocatalysts, Micro and Nano Technologies; Elsevier: Amsterdam, The Netherlands, 2021; pp. 1–6. [Google Scholar] [CrossRef]
- Hao, X.; Jia, J.; Chang, Y.; Jia, M.; Wen, Z. Monodisperse copper selenide nanoparticles for ultrasensitive and selective non-enzymatic glucose biosensor, Electrochim. Acta 2019, 327, 135020. [Google Scholar] [CrossRef]
- Hessel, C.M.; Pattani, V.P.; Rasch, M.; Panthani, M.G.; Koo, B.; Tunnell, J.W.; Korgel, B.A. Copper Selenide Nanocrystals for Photothermal Therapy. Nano Lett. 2011, 11, 2560–2566. [Google Scholar] [CrossRef] [PubMed]
- Dong, H.; Quintilla, A.; Cemernjak, M.; Popescu, R.; Gerthsen, D.; Ahlswede, E.; Feldmann, C. Colloidally stable selenium@copper selenide core@shell nanoparticles as selenium source for manufacturing of copper–indium–selenide solar cells. J. Colloid Interface Sci. 2014, 415, 103–110. [Google Scholar] [CrossRef] [PubMed]
- Singh, S.C.; Li, H.; Yao, C.; Zhan, Z.; Yu, W.; Yu, Z.; Guo, C. Structural and compositional control in copper selenide nanocrystals for light-induced self-repairable electrodes. Nano Energy 2018, 51, 774–785. [Google Scholar] [CrossRef] [PubMed]
- Liu, X.; Law, W.-C.; Jeon, M.; Wang, X.; Liu, M.; Kim, C.; Prasad, P.N.; Swihart, M.T. Cu2–xSe Nanocrystals with Localized Surface Plasmon Resonance as Sensitive Contrast Agents for in Vivo Photoacoustic Imaging: Demonstration of Sentinel Lymph Node Mapping. Adv. Healthc. Mater. 2013, 2, 952–957. [Google Scholar] [CrossRef]
- Patel, S.R.; Chaki, S.H.; Giri, R.K.; Khimani, A.J.; Vaidya, Y.H.; Thakor, P.; Thakkar, A.B.; Deshpande, M.P. Pristine, Ni- and Zn—Doped CuSe Nanoparticles: An Antimicrobial, Antioxidant, and Cytotoxicity Sutdy. ACS Appl. Bio. Mater. 2023, 6, 2211. [Google Scholar] [CrossRef] [PubMed]
- Shi, Y.; Li, Y.; Huang, C.; Xu, Y.; Xu, Y. Electrogenerated copper selenide with positive charge to efficiently capture and combat drug-resistant bacterial for wound healing. J. Colloid Interface Sci. 2023, 634, 852–863. [Google Scholar] [CrossRef] [PubMed]
- Yang, D.; Zhu, Q.; Chen, C.; Liu, H.; Liu, Z.; Zhao, Z.; Zhang, X.; Liu, S.; Han, B. Selective electroreduction of carbon dioxide to methanol on copper selenide nanocatalysts. Nat. Commun. 2019, 10, 677. [Google Scholar] [CrossRef] [PubMed]
- Yu, J.; Li, Z.; Liu, T.; Zhao, S.; Guan, D.; Chen, D.; Shao, Z.; Ni, M. Morphology control and electronic tailoring of CoxAy (A = P, S, Se) electrocatalysts for water splitting. Chem. Eng. J. 2023, 460, 141674. [Google Scholar] [CrossRef]
- Lie, S.Q.; Wang, D.M.; Gao, M.X.; Huang, C.Z. Controllable copper deficiency in Cu2-x Se nanocrystals with tunable localized surface plasmon resonance and enhanced chemiluminescence. Nanoscale 2014, 6, 10289–10296. [Google Scholar] [CrossRef]
- Rasheed, M.; Saira, F.; Batool, Z.; Yaseen, J.; Arshad, M.; Kalsoom, A.; Ahmed, H.E.; Ashiq, M.N. Facile synthesis of a CuSe/PVP nanocomposite for ultrasensitive non-enzymatic glucose biosensing. RSC Adv. 2023, 13, 26755–26765. [Google Scholar] [CrossRef]
- Iqbal, M.; Bhatti, H.N.; Younis, S.; Rehmat, S.; Alwadai, N.; Almuqrin, A.H.; Iqbal, M. Graphene oxide nanocomposite with CuSe and photocatalytic removal of methyl green dye under visible light irradiation. Diam. Relat. Mater. 2021, 113, 108254. [Google Scholar] [CrossRef]
- Alharbi, F.F.; Ahmad, Z.; Chughtai, A.H.; Khosa, R.Y.; Farid, H.M.T. Designing CuSe-gCN nanocomposite as an active electrocatalyst for water oxidation. Korean J. Chem. Eng. 2023, 40, 2303–2311. [Google Scholar] [CrossRef]
- Nguyen, N.T.T.; Nguyen, L.M.; Nguyen, T.T.T.; Nguyen, T.T.; Van Tran, T. Formation, antimicrobial activity, and biomedical performance of plant-based nanoparticles: A review. Environ. Chem. Lett. 2022, 20, 2531–2571. [Google Scholar] [CrossRef]
- Donald-Heyding, R.; MacLaren Murray, R. The crystal structures of Cu1.8Se, Cu3Se2, α- and γCuSe, CuSe, and CuSe2 II. Can. J. Chem. 1976, 54, 841–848. [Google Scholar] [CrossRef]
- Gosavi, S.R.; Deshpande, N.G.; Gudage, Y.G.; Sharma, R. Physical, optical and electrical properties of copper selenide (CuSe) thin films deposited by solution growth technique at room temperature. J. Alloys Compd. 2008, 448, 344–348. [Google Scholar] [CrossRef]
- Shafizade, R.B.; Ivanova, I.V.; Kazinets, M.M. Electron diffraction study of phase transformations of the compound CuSe. Thin Solid Films 1978, 55, 211–220. [Google Scholar] [CrossRef]
- Bhuse, V.M.; Hankare, P.P.; Garadkar, K.M.; Khomane, A.S. A simple, convenient, low temperature route to grow polycrystalline copper selenide thin films. Mater. Chem. Phys. 2003, 80, 82–88. [Google Scholar] [CrossRef]
- Senthilkumar, M.; Imla Mary, C.; Moorthy Babu, S. Morphological controlled synthesis of hierarchical copper selenide nanocrystals by Oleic acid, 1-Dodecanethiol and 1-Octadecene as surfactants. J. Cryst. Growth 2017, 468, 169–174. [Google Scholar] [CrossRef]
- Abraham, A.; Tarachand; Okram, G.S.; Jacob, R.; Sreenivasan, P.V.; Reena Philip, R. Low temperature electrical conductivity and seebeck coefficient of nanostructured CuSe thin films with Ga addition. Vacuum 2016, 129, 74–78. [Google Scholar] [CrossRef]
- Chen, X.; Li, Z.; Yang, J.; Sun, Q.; Dou, S. Aqueous preparation of surfactant-free copper selenide nanowires. J. Colloid Interface Sci. 2015, 442, 140–146. [Google Scholar] [CrossRef]
- Gurin, V.S.; Alexeenko, A.A.; Zolotovskaya, S.A.; Yumashev, K.V. Copper and copper selenide nanoparticles in the sol-gel metrices: Structural and optical. Mater. Sci. Eng. C 2006, 26, 952–955. [Google Scholar] [CrossRef]
- Liu, K.; Liu, H.; Wang, J.; Shi, L. Synthesis and characterization of Cu2Se prepared by hydrothermal co-reduction. J. Alloys Compd. 2009, 484, 674–676. [Google Scholar] [CrossRef]
- Hu, H.; Ge, X.; Deng, C.; Sun, M.; Xuan, H.; Zhang, K. Copper selenide (CuSe and Cu2Se) nanocrystals: Controllable synthesis through a facile ultrasonic chemical route. Asian J. Chem. 2013, 25, 5516–5518. [Google Scholar] [CrossRef]
- Liew, J.Y.C.; Talib, Z.A.; Zainal, Z.; Ahmad Kamarudin, M.; Osman, N.H.; Kee Lee, H. Structural and transport mechanism studies of copper selenide nanoparticles. Semicond. Sci. Technol. 2019, 34, 125017. [Google Scholar] [CrossRef]
- Huang, P.; Kong, Y.; Li, Z.; Gao, F.; Cui, D. Copper Selenide Nanosnakes: Bovine Serum Albumin-Assisted Room Temperature Controllable Synthesis and Characterization. Nanoscale Res Lett. 2010, 5, 949–956. [Google Scholar] [CrossRef][Green Version]
- Patidar, D.; Saxena, N.S. Characterization of single phase copper selenide nanoparticles and their growth mechanism. J. Cryst. Growth 2012, 343, 68–72. [Google Scholar] [CrossRef]
- Mancillas-Salas, S.; Ledón-Smith, J.Á.; Pérez-Álvarez, M.; Cadenas-Pliego, G.; Mata-Padilla, J.M.; Andrade-Guel, M.; Esparza-González, S.C.; Vargas-Gutiérrez, G.; Sierra-Gómez, U.A.; Saucedo-Salazar, E.M. Nanostructured Copper Selenide Coatings for Antifouling Applications. Polymers 2024, 16, 489. [Google Scholar] [CrossRef] [PubMed]
- Balouiri, M.; Sadiki, M.; Ibnsouda, S.K. Methods for in vitro evaluating antimicrobial activity: A review. J. Pharm. Anal. 2016, 6, 71–79. [Google Scholar] [CrossRef] [PubMed]
- Clinical and Laboratory Standards Institute (CLSI). CLSI Standard M07; Methods for Dilution Antimicrobial Susceptibility Tests for Bacteria That Grow Aerobically. 11th ed, Clinical and Laboratory Standards Institute: Wayne, PA, USA, 2018; ISBN 1-56238-837-1. [Google Scholar]
- Xie, Y.; Zheng, X.; Jiang, X.; Lu, J.; Zhu, L. Sonochemical Synthesis and Mechanistic Study of Copper Selenides Cu2-xSe, β-CuSe, and Cu3Se2. Inorg. Chem. 2002, 41, 387–392. [Google Scholar] [CrossRef]
- Venkatesham, M.; Ayodhya, D.; Madhusudhan, A.; Veerabhadram, G. Synthesis of Stable Silver Nanoparticles Using Gum Acacia as Reducing and Stabilizing Agent and Study of Its Microbial Properties: A Novel Green Approach. Int. J. Green Nanotechnol. 2012, 4, 199–206. [Google Scholar] [CrossRef]
- Mazhar, M.; Bakhtawar, S.; Rana, A.; Usmani, M.; Akhtar, N.; Abbas, W.; Khan, K.; Ahmad, J. Insight into the Structural Characterization of Pure and Zr-Doped Hydrothermally Synthesized Cerium Oxide Nanoparticles. Mater. Res. Express 2019, 6, 105022. [Google Scholar] [CrossRef]
- Vieira, A.P.; Stein, E.M.; Andregietti, D.X.; Cebrián-Torrejón, G.; Doménech-Carbó, A.; Colepicolo, P.; Ferreira, A.M.D.C. “Sweet chemistry”: A green way for obtaining selenium nanoparticles active against cancer cells. J. Braz. Chem. Soc. 2017, 28, 2021–2027. [Google Scholar] [CrossRef]
- Souza, L.M.D.S.; Dibo, M.; Sarmiento, J.J.P.; Seabra, A.B.; Medeiros, L.P.; Lourenço, I.M.; Kobayashi, R.K.T.; Nakazato, G. Biosynthesis of selenium nanoparticles using combinations of plant extracts and their antibacterial activity. Curr. Res. Green Sustain. Chem. 2022, 5, 100303. [Google Scholar] [CrossRef]
- Jiang, F.; Cai, W.; Tan, G. Facile Synthesis and Optical Properties of Small Selenium Nanocrystals and Nanorods. Nanoscale Res. Lett. 2017, 12, 401. [Google Scholar] [CrossRef]
- Pérez-Alvarez, M.; Cadenas-Pliego, G.; Pérez-Camacho, O.; Comparán-Padilla, V.E.; Cabello-Alvarado, C.J.; Saucedo-Salazar, E. Green Synthesis of Copper Nanoparticles Using Cotton. Polymers 2021, 13, 1906. [Google Scholar] [CrossRef]
- Velayati, M.; Hassani, H.; Sabouri, Z.; Mostafapour, A.; Darroudi, M. Biosynthesis of Se-Nanorods using Gum Arabig (GA) and Investigation of Their Photocatalytic and Cytotoxicity Effects. Inorg. Chem. Commun. 2021, 128, 108589. [Google Scholar] [CrossRef]
- Shitu, I.G.; Talib, Z.A.; Chi, J.L.Y.; Kechick, M.M.A.; Baqiah, H. Influence of Tartaric Acid Concentration on Structural and Optical Properties of CuSe Nanoparticles Synthesized Via Microwave Assisted Method. Results Phys. 2020, 17, 103041. [Google Scholar] [CrossRef]
- Daoub, R.M.A.; Elmubarak, A.H.; Misran, M.; Hassan, E.A.; Osman, M.E. Characterization and Functional Properties of Some Natural Acacia Gums. J. Saudi Soc. Agric. Sci. 2018, 17, 241–249. [Google Scholar] [CrossRef]
- Zohuriaan, M.J.; Shokrolahi, F. Thermal Studies on Natural and Modified Gums. Polym. Test. 2004, 23, 575–579. [Google Scholar] [CrossRef]
- Jamaludin, J.; Adam, F.; Rasid, R.A.; Hassan, Z. Thermal Studies on Arabic Gum—Carrageenan Polysaccharides Film. Chem. Eng. Res. Bull. 2017, 19, 80–89. [Google Scholar] [CrossRef]
- Nawaz, M.; Shakoor, R.; Kahraman, R.; Montemor, M. Cerium Oxide Loaded with Gum Arabic as Environmentally Friendly Anti-Corrosion Additive for Protection of Coated Steel. Mater. Des. 2021, 198, 109361. [Google Scholar] [CrossRef]
- Amir, M.; Farooq, M.; Ambreen, J.; Ahmad, N.; Iqbal, M.; Haleem, A.; Saeed, S.; Shah, A.; Siddiq, M. Synthesis and Characterization of Gum Arabic Microgels Stabilizing Metal Based Nanocatalysts for Ultrafast Catalytic Reduction of 4-Nitrophenol at Ambient Conditions. J. Environ. Chem. Eng. 2019, 7, 103280. [Google Scholar] [CrossRef]
- Farooq, M.; Sagbas, S.; Mildiz, M.; Meral, K.; Siddiq, M.; Aktas, N.; Sahiner, N. Gum Arabic Microgels as Template for in Situ Metal-Sulfide Based Quantum Dots Preparation and Their Thermal, Spectroscopic, Optical, and Magnetic Characterization. J. Electron. Mater. 2017, 46, 4373–4383. [Google Scholar] [CrossRef]
- Liu, Q.; Wu, J.; Wang, P.; Lu, Y.; Ban, X. Neutral Polysaccharides From Hohenbuehelia serotina With Hypoglycemic Effects in a Type 2 Diabetic Mouse Model. Front. Pharmacol. 2022, 13, 883653. [Google Scholar] [CrossRef]
- Jadhav, A.A.; Khanna, P.K. Impact of Microwave Irradiation on Cyclo-Octeno1,2,3-Selenadiazole: Formation of Selenium Nanoparticles and Their Polymorphs. RSC Adv. 2015, 5, 44756–44763. [Google Scholar] [CrossRef]
- Saltana, F.; Hakan, A. Synthesis and thermal degradation Kinetics of D-(+)-galacotse containing polymers. Polímeros 2013, 23, 697–704. [Google Scholar] [CrossRef]
- Chen, Z.; Shen, Y.; Xie, A.; Zhu, J.; Wu, Z.; Huang, F. L-Cysteine-Assisted Controlled Synthesis of Selenium Nanospheres and Nanorods. Cryst. Growth Des. 2009, 9, 1327. [Google Scholar] [CrossRef]
- Zhang, S.; Huang, Q.; Zhang, L.; Zhang, H.; Han, Y.; Sun, Q.; Cheng, Z.; Qin, H.; Dou, S.; Li, Z. Vacancy Engineering of Cu2-xSe Nanoparticles with Tunable LSPR and Magnetism for Dual-Modal Imaging Guided Photothermal Therapy of Cancer. Nanoscale 2018, 10, 3130–3143. [Google Scholar] [CrossRef]
- Gobeaut, A.; Laffont, L.; Tarascon, J.M.; Parissi, L.; Kerrec, O. Influence of secondary phases during annealing on re-crystallization of CuInSe2 electrodeposited films. Thin Solid Films 2009, 517, 4436–4442. [Google Scholar] [CrossRef]
- Wolf, D.; Müller, G. Kinetics of CIS-formation studied in situ by thin film calorimetry. Thin Solid Film 2000, 361, 155–160. [Google Scholar] [CrossRef]
- Venegas del Castillo, A.; Vásquez-Valles, M.N. Efecto Del Aceite Esencial De Lantana Camara Sobre El Crecimiento De Staphylococcus Aureus y Escherichia coli. REBIOL 2020, 36, 29–37. Available online: https://revistas.unitru.edu.pe/index.php/facccbiol/article/view/1311 (accessed on 16 June 2024).

| Sample | Concentration (% wt.) | Microorganism | Average Inhibition Diameter (mm) and Standard Deviation |
|---|---|---|---|
| CL S.A. | 0 | Staphylococcus aureus | 0 |
| 1.0% S.A. | 1.0 | Staphylococcus aureus | 15.1 ± 1.2 |
| 2.0% S.A. | 2.0 | Staphylococcus aureus | 21.1 ± 2.9 |
| 3.0% S.A. | 3.0 | Staphylococcus aureus | 23.9 ± 3.3 |
| 4.0% S.A. | 4.0 | Staphylococcus aureus | 24.0 ± 2.2 |
| 8% S.A. | 8.0 | Staphylococcus aureus | 29.2 ± 1.8 |
| CL C. | 0 | Candida albicans | 0 |
| 1.0% C. | 1.0 | Candida albicans | 8.1 ±1.8 |
| 2.0% C. | 2.0 | Candida albicans | 15.2 ± 1.0 |
| 3.0% C. | 3.0 | Candida albicans | 17.3 ± 1.0 |
| 4.0% C. | 4.0 | Candida albicans | 18.3 ± 2.2 |
| 8.0% C. | 8.0 | Candida albicans | 21.3 ± 1.2 |
| CL E.C. | 0 | Escherichia coli | 0 |
| 1.0% E.C. | 1.0 | Escherichia coli | 8.2 ± 0.70 |
| 2.0% E.C. | 2.0 | Escherichia coli | 11.9 ± 2.3 |
| 3.0% E.C. | 3.0 | Escherichia coli | 13.8 ± 2.0 |
| 4.0% E.C. | 4.0 | Escherichia coli | 15.6 ± 1.2 |
| 8.0% E.C. | 8.0 | Escherichia coli | 17.2 ± 0.40 |
Disclaimer/Publisher’s Note: The statements, opinions and data contained in all publications are solely those of the individual author(s) and contributor(s) and not of MDPI and/or the editor(s). MDPI and/or the editor(s) disclaim responsibility for any injury to people or property resulting from any ideas, methods, instructions or products referred to in the content. |
© 2024 by the authors. Licensee MDPI, Basel, Switzerland. This article is an open access article distributed under the terms and conditions of the Creative Commons Attribution (CC BY) license (https://creativecommons.org/licenses/by/4.0/).
Share and Cite
Mata-Padilla, J.M.; Ledón-Smith, J.Á.; Pérez-Alvarez, M.; Cadenas-Pliego, G.; Barriga-Castro, E.D.; Pérez-Camacho, O.; Cabello-Alvarado, C.J.; Silva, R. Synthesis and Superficial Modification “In Situ” of Copper Selenide (Cu2-x Se) Nanoparticles and Their Antibacterial Activity. Nanomaterials 2024, 14, 1151. https://doi.org/10.3390/nano14131151
Mata-Padilla JM, Ledón-Smith JÁ, Pérez-Alvarez M, Cadenas-Pliego G, Barriga-Castro ED, Pérez-Camacho O, Cabello-Alvarado CJ, Silva R. Synthesis and Superficial Modification “In Situ” of Copper Selenide (Cu2-x Se) Nanoparticles and Their Antibacterial Activity. Nanomaterials. 2024; 14(13):1151. https://doi.org/10.3390/nano14131151
Chicago/Turabian StyleMata-Padilla, José Manuel, José Ángel Ledón-Smith, Marissa Pérez-Alvarez, Gregorio Cadenas-Pliego, Enrique Díaz Barriga-Castro, Odilia Pérez-Camacho, Christian Javier Cabello-Alvarado, and Rodolfo Silva. 2024. "Synthesis and Superficial Modification “In Situ” of Copper Selenide (Cu2-x Se) Nanoparticles and Their Antibacterial Activity" Nanomaterials 14, no. 13: 1151. https://doi.org/10.3390/nano14131151
APA StyleMata-Padilla, J. M., Ledón-Smith, J. Á., Pérez-Alvarez, M., Cadenas-Pliego, G., Barriga-Castro, E. D., Pérez-Camacho, O., Cabello-Alvarado, C. J., & Silva, R. (2024). Synthesis and Superficial Modification “In Situ” of Copper Selenide (Cu2-x Se) Nanoparticles and Their Antibacterial Activity. Nanomaterials, 14(13), 1151. https://doi.org/10.3390/nano14131151

